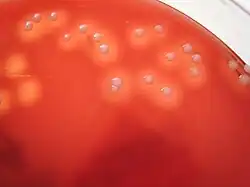

Microbiología

La microbiología es la ciencia encargada del estudio y el análisis de los microorganismos, seres vivos diminutos no visibles al ojo humano (del griego «μικρος» mikros "pequeño", «βιος» bios, "vida" y «-λογία» -logía, tratado, estudio, ciencia), también conocidos como microbios.[1] [2]
Se dedica a estudiar los organismos que son solo visibles a través del microscopio: organismos procariotas y eucariotas simples. Son considerados microbios todos aquellos seres vivos microscópicos, los cuales pueden estar constituidos por una sola célula (unicelulares), o por conjuntos de células. Los microorganismos pueden ser eucariotas (células que poseen envoltura nuclear) tales como hongos y protistas; o procariotas (células sin envoltura nuclear) como las bacterias. Sin embargo la microbiología tradicional se ha ocupado especialmente de los microorganismos patógenos entre bacterias, virus y hongos, dejando a otros microorganismos en manos de la parasitología y otras categorías de la biología.[3]
Aunque en las últimas décadas la microbiología se ha desarrollado considerablemente, todavía queda mucho por conocer y constantemente se efectúan nuevos descubrimientos en este campo. Tanto es así que, según las estimaciones más habituales, solo un 1 % de los microbios existentes en la biosfera han sido estudiados hasta el momento. Por lo tanto, a pesar de que han pasado más de 300 años desde el descubrimiento de los microorganismos, la ciencia de la microbiología se halla todavía en su infancia en comparación con otras disciplinas biológicas tales como la zoología, la botánica o incluso la entomología.[4]
Al tratar la microbiología sobre todo los microorganismos patógenos para el hombre, se relaciona con categorías de la medicina como patología, inmunología y epidemiología.[5]
Historia

La microbiología, como ciencia,[6] existe aproximadamente desde la segunda mitad del siglo XIX. Aunque el término bacteria, derivado del griego βακτηριον ("bastoncillo"), no fue introducido hasta el año 1828 por Christian Gottfried Ehrenberg, ya en 1676 Anton van Leeuwenhoek, usando un microscopio de una sola lente que él mismo había construido basado en el modelo creado por el erudito Robert Hooke en su libro Micrographia, realizó la primera observación microbiológica registrada de "animáculos", como van Leeuwenhoek los llamó y dibujó entonces.[7]
Eugenio Espejo (1747-1795) publicó importantes trabajos de medicina, como las Reflexiones acerca de la viruela (1785), el cual se convertiría en el primer texto científico que refería la existencia de microorganismos (inclusive antes que Louis Pasteur) y que definiría como política de salud conceptos básicos de la actualidad como la asepsia y antisepsia de lugares y personas.[8]
La bacteriología (más tarde una subdisciplina de la microbiología) se considera fundada por el botánico Ferdinand Cohn (1828-1898). Cohn fue también el primero en formular un esquema para la clasificación taxonómica de las bacterias.
Louis Pasteur (1822-1895), considerado el padre de la Microbiología Médica, y Robert Koch (1843-1910) fueron contemporáneos de Cohn. Quizá el mayor triunfo de Pasteur consistió en la refutación mediante cuidadosos experimentos de la por aquel entonces muy respetada teoría de la generación espontánea, lo cual permitió establecer firmemente a la microbiología dentro de las ciencias biológicas. Pasteur también diseñó métodos para la conservación de los alimentos (pasteurización) y vacunas contra varias enfermedades como el carbunco, el cólera aviar y la rabia. Robert Koch es especialmente conocido por su contribución a la teoría de los gérmenes de la enfermedad, donde, mediante la aplicación de los llamados postulados de Koch, logró demostrar que enfermedades específicas están causadas por microorganismos patogénicos específicos. Koch fue uno de los primeros científicos en concentrarse en la obtención de cultivos puros de bacterias, lo cual le permitió aislar y describir varias especies nuevas de bacterias, entre ellas Mycobacterium tuberculosis, el agente causal de la tuberculosis.
Mientras Louis Pasteur y Robert Koch son a menudo considerados los fundadores de la microbiología, su trabajo no reflejó fielmente la auténtica diversidad del mundo microbiano, dado su enfoque exclusivo en microorganismos de relevancia médica. Dicha diversidad no fue revelada hasta más tarde, con el trabajo de Martinus Beijerinck (1851-1931) y Sergei Winogradsky (1856-1953). Martinus Beijerinck hizo dos grandes contribuciones a la microbiología: el descubrimiento de los virus y el desarrollo de técnicas de cultivo microbiológico. Mientras que su trabajo con el virus del mosaico del tabaco estableció los principios básicos de la virología, fue su desarrollo de nuevos métodos de cultivo el que tuvo mayor impacto inmediato, pues permitió el cultivo de una gran variedad de microbios que hasta ese momento no habían podido ser aislados. Sergei Winogradsky fue el primero en desarrollar el concepto de quimiolitotrofía y de este modo revelar el papel esencial que los microorganismos juegan en los procesos geoquímicos. Fue el responsable del aislamiento y descripción por vez primera tanto de las bacterias nitrificantes como de las fijadoras de nitrógeno.
El cirujano inglés Joseph Lister (1827-1912) aportó pruebas indirectas de que los microorganismos eran agentes de enfermedades humanas, a través de sus estudios sobre la prevención de infecciones de heridas. Lister, impresionado por las investigaciones de Pasteur sobre la participación de los microorganismos en la fermentación y la putrefacción, desarrolló un método de cirugía antiséptica, con el fin de evitar que los microorganismos penetrasen en las heridas. Los instrumentos se esterilizaban con calor y se trataban los vendajes quirúrgicos con fenol, que de vez en cuando se empleaba para rociar el campo quirúrgico. Este método tuvo resultados muy satisfactorios y transformó la cirugía después de que Lister publicase sus resultados en 1867.Al mismo tiempo, aportaba pruebas indirectas sobre el papel de los microorganismos en las enfermedades, pues el fenol, que destruía las bacterias, evitaba las infecciones en las heridas.
Empirismo y especulación
El conocimiento humano sobre los efectos producidos por los microorganismos ha estado presente incluso desde antes de tener conciencia de su existencia; debido a procesos de fermentación provocados por levaduras se puede hacer pan, bebidas alcohólicas y productos derivados de la leche. En la antigüedad la causa de las enfermedades era atribuida a castigos divinos, fuerzas sobrenaturales o factores físicos (La palabra malaria significa “mal aire”, se creía que era el aire viciado de los pantanos el que provocaba esta enfermedad). Durante este periodo previo al descubrimiento de los microorganismos, los naturalistas solo podían especular sobre el origen de las enfermedades.
Tipos de microbiología
El campo de la microbiología puede ser dividido en varias subdisciplinas:
- Fisiología microbiana: estudio (a nivel bioquímico) del funcionamiento de las células microbianas. Incluye el estudio del crecimiento, el metabolismo y la regulación de este. Estrechamente relacionada con la genética microbiana.
- Genética microbiana: estudio de la organización y regulación de los genes microbianos y cómo estos regulan el funcionamiento de las células. Está muy relacionada con la biología molecular.
- Microbiología médica: estudio de los microorganismos que causan enfermedades en el ser humano, su transmisión, la patogénesis y su tratamiento. Muy relacionada con la medicina, la epidemiología, la farmacología y la salud pública.
- Microbiología veterinaria: estudio de los microorganismos que causan enfermedades en los animales, principalmente en los domésticos y en los de interés económico (reses, aves de corral, cerdos, ovejas, cabras, etc.).
- Microbiología ambiental: estudio de la función y diversidad de los microbios en sus entornos naturales. Incluye la ecología microbiana, la geomicrobiología, la diversidad microbiana y la biorremediación.
- Microbiología evolutiva: estudio de la evolución de los microbios. Incluye la sistemática y la taxonomía bacterianas.
- Microbiología industrial: estudia la explotación de los microorganismos para su uso en procesos industriales. Ejemplos son la fermentación industrial (obtención de bebidas alcohólicas), el tratamiento de aguas residuales, la producción de biológicos (vacunas, antídotos) y la producción de alimentos tales como yogur, queso, etc.[9] Muy cercana a la industria de la biotecnología, dado que mediante técnicas de ingeniería genética se sobreestimula la producción de ciertos metabolitos microbianos de interés económico (aminoácidos, antibióticos, ácidos orgánicos, vitaminas, etc.).
- Microbiología farmacéutica: estudia los microorganismos asociados con la fabricación de productos farmacéuticos.[10]
- Microbiología de los Alimentos: los análisis microbiológicos de alimentos son una herramienta eficaz, en la aceptación de un proceso. La interpretación de los resultados obtenidos en el laboratorio es lo más complejo del proceso de evaluación.[11]
- Microbiología sanitaria: estudio de los microorganismos que contaminan los alimentos y que los estropean o mediante los cuales pueden transmitir enfermedades a quienes los consumen.
- Microbiología agrícola: estudio de los microorganismos (especialmente los hongos y las bacterias) que se encuentran en los suelos destinados al cultivo de plantas de interés económico y de cómo estos interaccionan en conjunto de manera benéfica.
- Fitopatología: estudio de las enfermedades que ciertas especies de microorganismos (virus, bacterias, hongos, protistas y nematodos) causan en las plantas, principalmente en las de interés económico.
- Ecología microbiana: estudia el comportamiento que presentan poblaciones de microorganismos cuando interactúan en el mismo ambiente, estableciendo relaciones biológicas entre sí.
Subdisciplinas y otras disciplinas relacionadas
- Bacteriología: Estudio de los procariontes (bacterias, arqueas). También abarca el estudio de las micobacterias (micobacteriología).
- Virología: Estudio de los virus y agentes subvirales.
- Micología: Estudio de los hongos.
- Protozoología: Estudio de los protozoarios.
- Micropaleontología: Estudio de los microfósiles.
- Palinología: Estudio del polen y las esporas.
- Ficología: También llamada algología, es el estudio de las algas y microalgas.
Beneficios de la microbiología

Históricamente, los microorganismos han sido vistos de manera negativa a causa de su asociación con muchas enfermedades humanas y animales. Sin embargo, los microorganismos patológicos son un porcentaje muy minoritario dentro del total de microorganismos, la mayoría de los cuales desempeñan papeles absolutamente imprescindibles y que de no existir harían inviable la vida en la Tierra.[7] Algunos ejemplos son las bacterias que fijan nitrógeno atmosférico (posibilitando la vida de los organismos vegetales), las bacterias del ciclo del carbono (indispensables para reincorporar al suelo la materia orgánica) o la multitud de microorganismos que viven de manera simbiótica en nuestro tubo digestivo, sin las cuales la digestión no sería viable. Así pues, los "organismos superiores" (animales, plantas, etc.) no podríamos vivir de no ser por las funciones desempeñadas por estos seres microscópicos. Además, tienen amplias aplicaciones en el terreno industrial, como las fermentaciones (por ejemplo para la producción de bebidas alcohólicas o productos lácteos), la producción de antibióticos o la de otros productos de interés farmacéutico o biotecnológico (hormonas, enzimas, etc.).[12] Finalmente, cabe también destacar el papel esencial que los microorganismos juegan en los laboratorios de investigación biológica de todo el mundo como herramientas para la clonación de genes y la producción de proteínas.
Refutación de la teoría de la generación espontánea

En el siglo XIX tuvo lugar una gran polémica sobre la teoría de la generación espontánea. La idea básica de la generación espontánea puede comprenderse fácilmente. El alimento se pudre si permanece durante cierto tiempo a la intemperie. Cuando este material putrefacto se examina al microscopio, se observa que está repleto de bacterias. ¿De dónde provienen estas bacterias que no se ven en el alimento fresco? Algunos pensaban que provenían de semillas o gérmenes que llegaban al alimento a través del aire, mientras otros opinaban que se originaban espontáneamente a partir del material inerte.
El adversario más ferviente de la generación espontánea fue el químico francés Louis Pasteur, cuyo trabajo sobre este problema fue el más riguroso y convincente. En primer lugar, Pasteur demostró que en el aire había estructuras que se parecían mucho a los microorganismos encontrados en el material putrefacto. Descubrió que el aire normal contiene continuamente una diversidad de células microbianas que son indistinguibles de las que se encuentran en mucha mayor cantidad en los materiales en putrefacción. Por tanto, concluyó que los organismos encontrados en tales materiales se originaban a partir de microorganismos presentes en el aire. Además postuló que dichas células en suspensión se depositan constantemente sobre todos los objetos. Pasteur pensó que si sus conclusiones eran correctas, entonces no debería estropearse un alimento tratado, de tal modo que todos los organismos que lo contaminaran fueran destruidos.
Pasteur empleó el calor para eliminar los contaminantes, pues ya se sabía que el calor destruye con efectividad los organismos vivos. De hecho, otros investigadores ya habían mostrado que si una solución de nutrientes se introducía en un matraz de vidrio, se sellaba y se calentaba luego hasta ebullición, nunca se descomponía. Los defensores de la generación espontánea criticaban tales experimento argumentando que se necesitaba aire fresco para la generación espontánea y que el aire dentro del matraz cerrado se modificaba por el calentamiento, de modo que no era capaz de permitir la generación espontánea. Pasteur superó esta objeción de modo simple y brillante, construyendo un matraz con forma de cuello de cisne, que ahora se designa como un matraz Pasteur. En tales recipientes, las soluciones nutritivas se podían calentar hasta ebullición; luego, cuando el matraz se enfriaba, el aire podía entrar de nuevo, pero la curvatura del cuello del matraz, evitaba que el material particulado, las bacterias y otros microorganismos, alcanzasen el interior del matraz. El material esterilizado en tal recipiente no se descomponía y no aparecían microorganismos mientras el cuello del matraz no contactara con el líquido estéril. Sin embargo, bastaba con que el cuello del matraz se inclinara lo suficiente como para permitir que el líquido estéril contactara con el cuello, para que ocurriera la putrefacción y el líquido se llenara de microorganismos. Este sencillo experimento bastó para aclarar definitivamente la controversia sobre la generación espontánea.
Eliminar todas las bacterias o microorganismos de un objeto es un proceso que ahora denominamos esterilización. Los procedimientos que usaron Pasteur, Cohn y otros investigadores fueron finalmente mejorados y aplicados a la investigación microbiológica. El fin de la teoría de la generación espontánea condujo, por tanto, al desarrollo de procedimientos eficaces de esterilización, sin los cuales la microbiología no podría haberse desarrollado como ciencia.[13]
La microbiología en la actualidad
Actualmente, el conocimiento microbiológico se ha especializado tanto que lo encontramos divididos: la microbiología médica estudia los microorganismos patógenos y la posible cura para las enfermedades que producen, la inmunología averigua las causas de la aparición de las enfermedades desde una perspectiva inmunológica, la microbiología ecológica estudia el nicho que le corresponde a los microorganismos en el medio, la microbiología agricultural las relaciones existentes entre plantas y microorganismos, y la biotecnología los posibles beneficios que puede llevar para el hombre la explotación de microbios.[14]
Importancia
Los microbiólogos han hecho contribuciones a la biología y a la medicina, especialmente en los campos de la bioquímica, genética y biología celular. Los microorganismos tienen muchas características que los hacen "organismos modelo" ideales:
- Son pequeños, por lo cual no consumen muchos recursos.
- Algunos tienen tiempos de generación muy cortos: el tiempo necesario para que una célula bacteriana se divida en dos en condiciones óptimas es de 20 minutos aproximadamente para E. coli en un medio rico y a 37 °C. Sin embargo, hay bacterias con tiempos de generación más largos, como Mycobacterium tuberculosis, que es de 12 a 24 horas.[15]
- Las células pueden sobrevivir fácilmente separadas de otras células.
- Los eucariontes unicelulares se reproducen por división mitótica y los procariontes mediante fisión binaria. Esto permite la propagación de poblaciones clónicas genéticamente iguales.
- Pueden ser almacenados mediante congelación por grandes períodos de tiempo. Generalmente se preparan alícuotas conteniendo millones de microorganismos por mililitro por lo que aún y cuando el 90 % de las células mueran en el proceso de congelación, aún podrían obtenerse células viables.
La importancia de la microbiología se fundamenta en sus repercusiones en variados aspectos de la vida cotidiana, que no se limitan en forma excluyente a las ciencias de la salud. Por el contrario, el conocimiento de las formas de vida microscópicas genera impacto en áreas como la industria, los recursos energéticos y la administración pública.[16] Si bien se postulaba desde antaño la existencia de microorganismos, fue sin dudas Luis Pasteur quien se encargó de sistematizar los conceptos actuales de microbiología, echando por tierra las ideas de la generación espontánea y poniendo de manifiesto la real importancia de esta ciencia.[17] En la actualidad, ha sido tal el crecimiento de la microbiología como rama que muchos especialistas han optado por dividirla y, así, considerar como disciplinas independientes a la microbiología clínica, la microbiología general, la microparasitología y la micología, entre otras.
Microbiología y ODS
Los Objetivos de Desarrollo Sostenible (ODS) contemplan 17 objetivos globales, entre los que encontramos la erradicación de la pobreza, la desigualdad y el hambre; así como el acceso a la salud, el agua potable, y la educación. También contempla objetivos ambientales como la acción contra el cambio climático, y la preservación de la vida submarina y de los ecosistemas terrestres. En este contexto, la microbiología está estrechamente relacionada con los ODS y tiene un rol fundamental en su consecución. [18][19]
Los microorganismos son fundamentales para la sostenibilidad, ya que son una parte integral del Sistema Tierra a través de los ciclos biogeoquímicos, incluso descomponiendo y reciclando los residuos generados por la actividad humana. Son esenciales para lograr la seguridad alimentaria global y se ha demostrado que su actividad influye en los procesos climáticos a nivel mundial, lo que refuerza el potencial de la microbiología para abordar algunos de los desafíos climáticos globales. A continuación, se destacan algunos de los aportes de la ciencia microbiológica en la consecución de los 17 ODS.[19][20]
ODS 1: Fin de la Pobreza
En el mundo, hay millones de personas que viven en condiciones de extrema pobreza. Esto aumenta el riesgo de contraer enfermedades infecciosas por la falta de acceso a atención médica. La microbiología contribuye a este objetivo mediante el desarrollo de agentes antimicrobianos y vacunas. Así se combaten enfermedades que son prevalentes en comunidades en condiciones de pobreza, mejorando la calidad de vida.[21]
ODS 2: Hambre Cero
La microbiología tiene un papel clave a la hora de garantizar el acceso a alimentos nutritivos y seguros. Interviene en la producción y conservación de los alimentos, así como en su seguridad. Contribuye a controlar patógenos presentes en los alimentos, y así prevenir enfermedades. Además, La microbiología aborda la diversidad microbiana y salud del suelo, lo cual es un factor fundamental para la producción y seguridad alimentaria. También permite que tierras marginales sean cultivables mediante la incorporación de microorganismos, como hongos simbióticos, a fin de mejorar la fertilidad del suelo.[21]
ODS 3: Salud y Bienestar
El ODS 3 encuentra por barrera en su consecución la resistencia a los antimicrobianos (RAM), dado que esta prolonga las enfermedades y genera un incremento de la mortalidad. La microbiología contribuye a mitigar la RAM mediante el desarrollo de antibióticos, vacunas y probióticos, lo cual mejora la salud metabólica y optimiza los tratamientos.[21] Además, están surgiendo nuevos enfoques respecto el uso de los microorganismos para prevenir y tratar patologías a partir del estudio de los microbiomas y su influencia en la nutrición, la salud y las enfermedades. Por ejemplo, mediante microbiomas intestinales es posible beneficiar la producción de vitamina K.[22]
ODS 4: Educación de Calidad
Los microorganismos son fundamentales en sectores como la medicina y la agroindustria, por lo que su estudio debe ser central en la formación de la población. La percepción pública sobre los microorganismos es limitada y, a menudo, negativa. Por lo tanto, la incorporación de la microbiología en la educación y su refuerzo mediante la divulgación podría cambiar esta percepción, a fin de mejorar la comprensión de su importancia en la salud, el ambiente y la producción de alimentos.[21] Como consecuencia, la alfabetización microbiana no sólo capacita a la comunidad en conceptos básicos de microbiología y biotecnología, sino que también fomenta cambios de comportamiento positivos, como mejores hábitos de higiene que previenen enfermedades o el uso responsable de antibióticos en el tratamiento de infecciones animales y humanas.[19]
Véase también
Referencias
- ↑ Consejo Nacional de Especialidades Médicas (1996). Microbiología y Parasitología. Ministerio de Sanidad y Consumo- Ministerio de Educación y Cultura.
- ↑ RAE - ASALE (2014). «microbiología | Definición | Diccionario de la lengua española | RAE - ASALE». Consultado el 18 de abril de 2020.
- ↑ «La ciencia de la microbiología». McGraw Hill Medical. Consultado el 21 de septiembre de 2024.
- ↑ «UPC - Microbiologia». upc.com.mx. Consultado el 21 de septiembre de 2024.
- ↑ Mazana Casanova, Javier Sebastián (1991). Microbiología e inmunología. Una historia compartida. Universidad de Zaragoza. Consultado el 21 de septiembre de 2024.
- ↑ Ingraham, Ingraham, John, Catherine. «Capitulo 1». Introducción a la Microbiología. ISBN 84-291-1869-1.
- ↑ a b Tortora, Funke, Case (2007). «El mundo microbiano y usted». Introducción a la microbiología (Silvia Rondinone, trad.). Médica Panamericana. ISBN 978-950-06-0740-7.
- ↑ «REFLEXIONES SOBRE LAS VIRUELAS. Eugenio Espejo. 1785. (FACSIMIL) | PDF | Bienestar | Medicina». Scribd. Consultado el 21 de septiembre de 2024.
- ↑ «CAA: Capítulo VIII».
- ↑ Denyer, S. P.; Hodges, Norman A.; Gorman, S. P.; Hugo, W. B.; Russell, A. D. (2004). Hugo and Russell's pharmaceutical microbiology (7th ed edición). Blackwell Science. ISBN 978-1-4051-4103-1. OCLC 608623131. Consultado el 11 de mayo de 2021.
- ↑ CAC/GL 021 (1997). PRINCIPIOS PARA EL ESTABLECIMIENTO Y LA APLICACION DE CRITERIOS MICROBIOLOGICOS A LOS ALIMENTOS.
- ↑ ANMAT (2003). Guía de Interpretación de resultados microbiológicos en Alimentos.
- ↑ Madigan, Martinko, Parker (2004). «Control de crecimiento microbiano». Brock, Biología de los microorganismos. Pearson Educación. ISBN 84-205-3679-2.
- ↑ Madigan, Martinkon, Dunlap, Clark (2009). «Unidad 1 Principios de Microbiología». Brock Biología de los microorganismos (12.ª edición edición). Madrid: PERSON EDUCACION. p. 3. ISBN 978-84-7829-097-0.
- ↑ «Ciclo celular y crecimiento». www.ugr.es. Consultado el 21 de septiembre de 2024.
- ↑ Madigan, Martinko, Parker (2004). «"Microorganismos y microbiologia"». Brock, Biología de los microorganismos. Pearson Educación. p. 8. ISBN 84-205-3679-2.
- ↑ Madigan, Martinko, Parker (2004). Brock, Biología de los microorganismos. Pearson Educación. pp. 10-11. ISBN 84-205-3679-2.
- ↑ Gamez, Maria Jose. «Objetivos y metas de desarrollo sostenible». Desarrollo Sostenible. Consultado el 21 de septiembre de 2024.
- ↑ a b c Akinsemolu, Adenike A. (2018-05). «The role of microorganisms in achieving the sustainable development goals». Journal of Cleaner Production (en inglés) 182: 139-155. doi:10.1016/j.jclepro.2018.02.081. Consultado el 21 de septiembre de 2024.
- ↑ Pearce, David A (17 de enero de 2024). «Announcing sustainable microbiology: How microbes make a sustainable world». Sustainable Microbiology (en inglés) 1 (1). ISSN 2755-1970. doi:10.1093/sumbio/qvae001. Consultado el 21 de septiembre de 2024.
- ↑ a b c d Fagunwa, Omololu E.; Olanbiwoninu, Afolake A. (1 de mayo de 2020). «Accelerating the sustainable development goals through microbiology: some efforts and opportunities». Access Microbiology (en inglés) 2 (5). ISSN 2516-8290. PMC 7494191. PMID 32974577. doi:10.1099/acmi.0.000112. Consultado el 21 de septiembre de 2024.
- ↑ Timmis, Kenneth; de Vos, Willem M.; Ramos, Juan Luis; Vlaeminck, Siegfried E.; Prieto, Auxiliadora; Danchin, Antoine; Verstraete, Willy; de Lorenzo, Victor et al. (2017-09). «The contribution of microbial biotechnology to sustainable development goals». Microbial Biotechnology (en inglés) 10 (5): 984-987. ISSN 1751-7915. PMC 5609250. PMID 28840974. doi:10.1111/1751-7915.12818. Consultado el 21 de septiembre de 2024.
Bibliografía
- Kreft, J.-U.; Plugge, C. M.; Grimm, V.; Prats, C.; Leveau, J. H. J. «Mighty small: Observing and modeling individual microbes becomes big science» Proceedings of the National Academy of Sciences, 110, 45, 05-11-2013, pàg. 18027–18028. DOI: 10.1073/pnas.1317472110. ISSN: 0027-8424. PMC: PMC3831448. PMID: 24194530.
- Madigan M.T., Martinko J.M., Dunlap P-V., Clark D.P. 2009. Brock. Biología de los microorganismos. Pearson Educación, Madrid, pp. 1296
Enlaces externos
Wikimedia Commons alberga una categoría multimedia sobre Microbiología.
Wikiversidad alberga proyectos de aprendizaje sobre Microbiología.- Bacteriology textbook.
- Sociedad Española de Microbiología. Archivado el 31 de agosto de 2012 en Wayback Machine.
- American Society for Microbiology.
- Society for General Microbiology.
- Historia de la Medicina Medieval y el origen de las enfermedades.